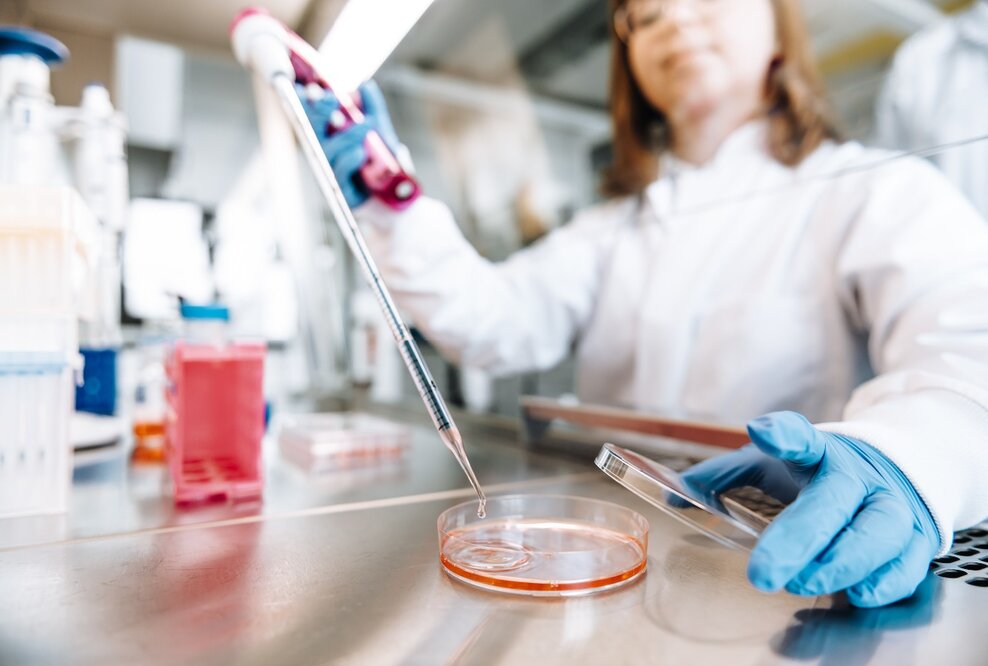
ASC Oncology beantwortet dank Testverfahren die zentrale Frage nach der Wirksamkeit von Krebsmedikamenten am Patiententumor

Für mindestens 1.000 Patienten jährlich wird es ab dem 1. Februar 2021 möglich sein, Therapieentscheidungen mithilfe von individuellen, an 3D-Organoid-Modellen ihres jeweiligen Tumors durchgeführten, Medikamententestungen zu treffen. Die Grundlage für das Reverse Clinical Engineering-Testverfahren sind 3D-Zellkulturmodelle (PD3D), sogenannte Organoide. Dabei handelt es sich um im Labor mithilfe einer Tumorprobe gezüchtete Abbilder des Ursprungstumors des Patienten. Organoide bestehen aus Zellclustern und behalten die komplexe Architektur des Ursprungstumors bei. An diesen testet ASC Oncology in Absprache mit dem behandelnden Onkologen unterschiedliche Krebsmedikamente und Wirkstoffkombinationen parallel. Erste Ergebnisse können dabei bereits nach zwei Wochen vorliegen. Eine Testung aller infrage kommender Therapieansätze dauert, je nach von der Aggressivität des Tumors abhängigen Wachstumsgeschwindigkeit der Organoide, vier bis sechs Wochen. Auf Grundlage der pathologischen und molekularbiologischen Daten kann ASC Oncology so auf wissenschaftlicher Basis mögliche wirksame Medikamente sowie Resistenzen voraussagen.
„Informationen helfen dabei, bessere Entscheidungen zu treffen − darum ist es unser Ziel, Patienten darin zu bestärken lebenswichtige Entscheidungen bestmöglich informiert zu treffen“, erläutert Dr. Christian Regenbrecht, Gründer von ASC Oncology und Entwickler des Reverse Clinical Engineering-Verfahrens. „ASC Oncology versteht sich dabei als Teamplayer, der den Onkologen mit dem angebotenen Testverfahren unterstützt, aber nicht ersetzt.“ Was in einigen Jahren vermutlich Routine in der Krebsbehandlung sein wird, ist durch ASC Oncology bereits 2021 für Betroffene und Onkologen anwendbar: Im Sinne der personalisierten Medizin die Behandlung von Krebs an jeden einzelnen Patienten effektiv und individuell anzupassen. Durch das Reverse Clinical Engineering-Verfahren werden Patienten die massiven Nebenwirkungen einer unnötigen Therapie erspart und wertvolle Zeit für die Behandlung gewonnen.
Um die Komplexität des Angebots zu vereinfachen, wird die Leistung in drei verschiedenen Paketen angeboten. Diese unterscheiden sich in der Anzahl der aufgearbeiteten Tumorgewebestücke, im Umfang der zu testenden Medikamente, in der Wahl einer zusätzlichen Protein-Analyse sowie einer optionalen Konservierung der Tumorzellen. Eine Übersicht über die verschiedenen Pakete und Kosten finden Sie unter
www.asc-oncology.com/preise. Das Testverfahren wird zum Selbstkostenpreis angeboten und ist zurzeit eine Individuelle Gesundheitsleistung (IGeL). Diese wird nicht von den Krankenkassen übernommen. Durch die Gründung des gemeinnützigen Cancer Rebels e.V. (www.cancer-rebels.club) bietet ASC Oncology Krebserkrankten mit geringen Mitteln unter anderem finanzielle Unterstützungsmöglichkeiten für die Nutzung des Testverfahrens an.
Wer ist ASC Oncology?
ASC Oncology wurde von neun führenden Wissenschaftlern der Kompetenzfelder Pathologie, Tumorbiologie, Biochemie, Biotechnologie und Molekularbiologie 2019 mit dem Ziel gegründet, sich der wichtigsten Herausforderung der modernen Onkologie anzunehmen: Patienten zur richtigen Zeit mit der richtigen Therapie zu versorgen. Dabei treten die Wissenschaftler von ASC Oncology an, durch das Reverse Clinical Engineering-Verfahren mehr Patienten besser zu versorgen als je zuvor in der Geschichte der Onkologie.
ASC Oncology − Rethink Oncology.
Die ausführliche Pressemappe sowie Pressebilder für Ihre Berichterstattung finden Sie im Pressebereich der Web-seite www.asc-oncology.com/presse.
Für Rückfragen steht Ihnen als erste Ansprechpartnerin Melanie Alperstaedt unter
@email oder +49 30 235 9467 76 zur Verfügung. Bei wissenschaftlichen Nachfragen oder Bedarf an einem Interview vermittelt sie Ihnen gern ein Experteninterview mit Dr. Christian Regenbrecht sowie weiteren Wissenschaftlern aus dem Team von ASC Oncology.